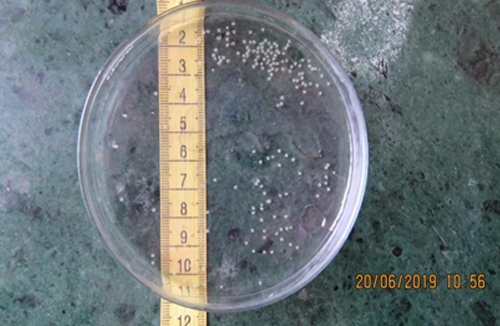

About College
Indian Fisheries sector has shown tremendous progress in last 50 years. Present Fish production in the country is more than 6 million tones out of which more than 50 % is contributed by Inland Fisheries sector. The Fisheries sector has shown steady growth rate of more than 7 % per annum. South Gujarat is endowed with 300 km. long coastline, very high rainfall and low outfall conditions with as many as 11 perennial rivers, 16 large reservoirs, hundreds of tanks and ponds is a predominantly fish producing area providing livelihood to 5 lakh families. This region contributes about 2/3rd of total Inland fishery production especially those of high value fishes like Catla, Rohu, Mrigal, Catfishes and Prawns. About 90 % of freshwater fish seed production through 8 hatcheries being carried out by South Gujarat region.
Know MoreAcademics

Degree programmes Offered
The College offers under-graduate Bachelor of Fisheries Science (B.F.Sc.) degree programmes in Fisheries Science with credit based semester system.
Explore